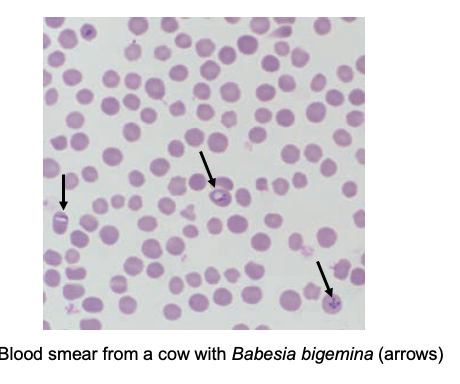
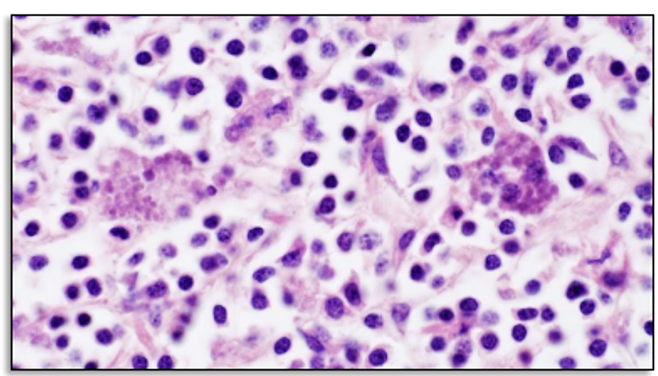
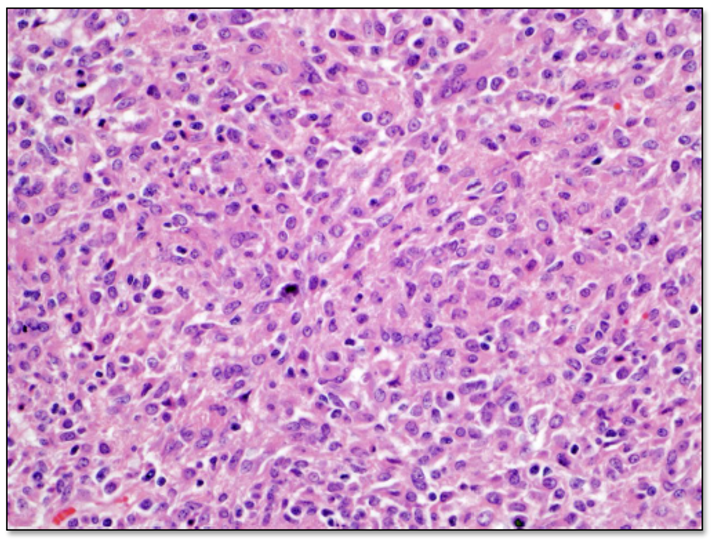

1/94
Looks like no tags are added yet.
Name | Mastery | Learn | Test | Matching | Spaced | Call with Kai |
|---|
No study sessions yet.
What tissues does the haematopoietic system involve? List some examples
Myeloid tissue —> bone marrow, blood cells, mononuclear phagocyte system
Lymphoid tissue —> lymph nodes, spleen, thymus, accessory lymphoid tissue
Define anaemia
Is a reduction in the number of erythrocytes and/or the haemoglobin concentration.
It is a clinical sign and not a disease
Caused by abnormally high RBC loss/destruction or decreased RBC formation.
What are the features of infectious anaemia?
Predominantly induce extravascular haemolysis —> hyperbilirubinaemia, jaundice, anaemia and splenomegaly
Lesions may be subtle or profound with gross finding depending on severity
List some examples of infectious anaemia
Equine infectious anaemia
Anaplasmosis
Haemotropic mycoplasma
Babesiosis
Trypanosomiasis
Theileriosis
Describe the pathogenesis of EIA (equine infectious anaemia aka swamp fever)
Infects cells of the monocyte-macrophage system, incl. megakaryocytes
Premature removal of platelets and erythrocytes coated in immune complexes
What is the name of the virus causing EIA? How is it transmitted?
Equine infectious anaemia virus (lentivirus)
Transmitted by flies, contaminated needles (mechanical not biological)
Describe the gross findings expected with EIA
Petechial haemorrhages esp. in kidney
Oedema of abdominal wall and suspensory ligaments
Enlarged liver and spleen
Red bone marrow (increased haematopoietic cells replacing fat)
Describe the histological findings expected with EIA
Increased cellularity of Bone marrow without increase in megakaryocytes
Describe the pathogenesis of anaplasmosis
Obligate intracellular bacterial infection of erythrocytes
Transmitted by ixodid ticks (biologically) and blood sucking flies, needles etc. (mechanically)
What is represented by the pale circular cells vs the purple dots?

Pale circular cells = RBCs
Purple dots = anaplasma bacterial cells
What are the aetiological agents cause anaplasmosis?
A. marginale
A. centrale (cattle)
A. ovis (sheep & goats)
How does anaplasmosis present grossly?
Pallor and jaundice, no pathognomic lesions
How does anaplasmosis present histologically?

What aetiological agents cause haemotropic mycoplasma?
M.haemofelis (cats),
M. haemocanis (spleenectomised/immunosuppressed dogs),
M. wenyonii (cattle)
Describe the pathogenesis of babesiosis
Apicomplexan protozoan, infects and replicates in erythrocytes -> lysis of RBCs
Transmitted by ticks, wide range of mammals
How does babesiosis present histologically?
See 2/4 pear-shaped merozoites(piroplasm) on blood smear

What aetiological agents cause babesiosis?
Cattle: Babesia bovis> B. bigemina in disease severity
How does babesiosis present grossly?
Congestion of gray matter in CNS
Recall the function, structure and circulation of lymph nodes
Function:
Filtration of lymph
Immune response
Structure:
Outer cortex -> follicles (mostly B cells)
Inner cortex -> paracortex (mostly T cells)
Medulla -> mostly B cells and macrophages

What is lymphadenopathy?
Enlargement of lymph node(s) of unknown cause
Can be localised or generalised
What can be the causes of enlarged lymph nodes?
Lymphadenitis
Lymphoid hyperplasia
Hyperplasia of the monocyte/macrophage system
Primary neoplasia e.g. lymphoma
Secondary Neoplasia
What can be the causes of small lymph nodes?
Lymphoid atrophy
Lymph node degeneration/necrosis
Lymph node hypoplasia
What is lymphadentitis?
An inflammatory response to an infectious agent within the node (as opposed to reactive hyperplasia which is an antigen driven immunologic response)
What is the difference between acute lymphadenitis and chronic lymphadenitis?

How does chronic suppurative lymphadenitis present grossly?
Swollen/enlarged lymph node with pus filled centre = lymph node abscess
Can fistulate to the skin surface
Response to pyogenic bacteria
How does chronic suppurative lymphadenitis present histologically?
Degenerate neutrophils
Lytic necrosis
Fibrous capsule
GIve a potential aetiological agnt causing chronic suppurative lymphadenitis and its pathogenesis
Porcine jowl abscess
A: Streptococcus porcinus
P: Colonises oral cavity/tonsils and spreads to the mandibular lymph nodes

Equine strangles
Aietiology: Streptococcus equi subsp equi
Pathogenesis: Inflammation of the URT → abscesses in the mandibular, retropharyngeal and parotid LNs
May fistulate to surface
Can spread to viscera → Bastard strangles

Caseous lymphadenitis
What are the potential sequelae to equine strangles?
Can get drainage to the guttural pouches
Suppurative/ purulent material → Guttural pouch empyema → inspissated (thickened/congealed) material → Chondroid formation

What aetiological agent causes caseous lymphadenitis (CLA), how does it differ between species?
Aeitiology—> Corynebacterium pseudotuberculosis
Chronic suppurative lymphadenitis in sheep and goats
Ulcerative lymphangitis in horses and cattle
Describe the pathogenesis of caseous lymphadenitis (CLA)
Usually enters via contamination of shear wounds; rarely by inhalation
Drains to regional lymph nodes
Superficial nodes more often affected than internal nodes
Prescapular LN /Prefemoral LN
How does CLA present grossly?
Enlargement of LN, as lesion progresses —> characteristic concentric laminations

How does CLA present histologically?
Chronic suppurative (neutrophils) inflammation, caseous necrosis and fibrosis
What are the subclasses of granulomatous lymphadentitis?
Nodular granulomatous lympadenitis
Diffuse granolmatous lymphadenitis
What is the difference in gross presentation between nodular and diffuse granulomatous lymphadenitis?
Nodular:
Focal or multifocal
Often white-yellow nodules
+/- caseous necrosis /mineralisation

Diffuse:
Enlarged, pale, dry, firm lymph nodes
Loss of architecture
Multifocal to coalescing

What aetiological agents can cause nodular granulomatous lymphadenitis?
Mycobacterium bovis (bovine tb)
Mycobacterium avium subsp. Paratuberculosis (Johne’s disease)
Actinobacillus lignieresii (wooden tongue)
Migrating parasitic larva
What are the potential causes of diffuse granulomatous lymphadenitis?
Porcine Circovirus type 2
Histoplasma capsulatum
Blastomyces dermatitidis
Cryptococcus neoformans
How does granulomatous lymphadenitis present histologically?
Macrophages, multinucleated giant cells, lymphocytes, plasma cells, fibrosis, necrosis +/- mineralisation
What is the aetiological agent causing bovine TB? How does it present grossly?
Mycobacterium bovis
Enlargement of the lymph node with single to multiple (multifocal) discrete yellow-tan gritty (caseated) nodules
Can disseminate to organs


How does bovine TB present histologically?
Granulomas with central necrosis and mineralisation surrounded by epithelioid macrophages and multinucleated giant cells
Lymphocytes + plasma cells



What aetiological agents causes Postweaning multisystemic wasting syndrome (PMWS)?
Porcine circovirus type 2
How does PMWS present grossly?
diffuse enlargement of mesenteric lymph nodes


(wastage of pig on left)
How does PMWS present histologically?
Granulomatous infiltration of the node with large botryoid intracytoplasmic viral inclusions
(botryoid = bunches of grapes appearance)

What can cause lymph node hyperplasia?
Benign reactive hyperplasia
What is the pathogenesis of benign reactive hyperplasia?
Immunological reaction = response to antigen presentation or circulating interleukin levels
Causes lymph node enlargement
Can be localised or generalised
Lymph nodes draining site of local infection or vaccination
Also occurs during early stages of lymphadenitis
How does benign reactive hyperplasia present grossly?
Moderate enlargement of the node(s) = lymphadenopathy
May bulge on cut section

How does benign reactive hyperplasia present histologically?
Proliferation of lymphoid follicles with prominent germinal centres
Increased T cells in the paracortex
+/ increased plasma cells in the medullary cords

What is being shown here?

Lymph node metastasis
Which tumours are common with lymph node metastasis?
Carcinomas, melanomas, mast cell tumours
How can you stage LN tumour malignancy?
Stage 0: regional node normal
Stage 1: regional node enlarged but still freely moveable
Stage 2: regional node enlarge and fixed
Summary of primary haemotopoietic neoplasias

What can cause lymphoproliferative disease?
Lymphoma
Neoplastic disorders of lymphocytes
Lymphoid leukaemia —> neoplastic lymphocytes in bone marrow/blood
Lymphoma —> neoplastic lymphocytes in tissues/organs
(becomes leukemic when spreads to bloodstream & BM)
How is lymphoma classified?
Anatomical classification —> multicentric, alimentary, thymic, cutaneous, miscellaneous, leukaemic
Biological behaviour —> low grade, intermediate grade, aggressive
Cellular morphology —> cell size, nuclear features, mitotic rate
Immunophenotype —> B-cell, T-cell, non B/T
What are the clinical signs of lymphoma?
Nonspecific signs —> Weight loss and loss of appetite
Painless swelling of 1+ lymph nodes: Lymphadenopathy
Other signs depend on anatomical location:
Retrobulbar lymph node —> exophthalmos
Thymic —> dyspnea, oesophageal obstruction
Alimentary —> diarrhoea, obstruction or melena
What do enlarged lymph nodes look/feel like grossly?
Soft to firm, bulge on cut surface, homogenous
Pale white to tan
Immobile

Describe canine lymphoma
Affects middle aged to older
Usually medium to high grade
No known viral association
Hypercalcaemia of malignancy
What is myelophthisis?
Complete replacement of haematopoietic tissue in BM by neoplasia/fibrosis/other abnormal tissue

What are the causes of lymphoma?
Viral infection —> Cats, cattle, mice, chickens
Hereditary —> porcine
Unknown (sporadic)
Which types of feline lymphoma are most common vs least common
Alimentary (most common)
Multicentric
Thymic
Miscallaneous forms (least common)
What is feline lymphoma associated with?
Feline leukemia virus (FeLV)
Young cats
Mediastinal or multicentric form
What are the forms of bovine lymphoma?
Enzootic bovine lymphoma (notifiable)
Sporadic bovine lymphoma
What is enzootic bovine lymphoma?
Multicentric lymphoma of B cell origin —> affects adult cattle esp. dairy
What is the aetiological agent causing enzootic bovine lymphoma?
Bovine leukosis virus (retrovirus)
How is enzootic bovine lymphoma transmitted?
Direct contact, natural breeding, contaminated needles, dehorning and ear-tagging equipment, arthropods
What are the commonly affected sites of enzootic bovine lymphoma?
Lymph node, right atrium, abomasum, spinal canal, uterus, kidney

What are the three forms of sporadic bovine lymphoma? What animals does each effect?
Young animals in the three forms
Calf form —> <6 months old
Juvenile form = thymic form —> yearling beef cattle
Cutaneous form —> 2-3 year old cattle
How does each form of sporadic bovine lymphoma present grossly?
Calf form —> Symmetrical lymphadenopathy and leukaemia, terminally = BM involvement ± organ infiltration
Juvenile form —> Mediastinal mass
Cutaneous —> Plaque like to nodular, round, raised skin lesions
Describe porcine lymphoma
Multcentric
Often <1 yo
More common in F vs M
Hereditary predisposition in large white pigs

Describe equine lymphoma
Subcut form in F
Alimentary, abdo, splenic & multicentric forms

Recall the anatomy, structure and function of the thymus
Anatomy
White to pink, lobulated organ within the anterior mediastinum.
Ruminants and pigs have a large cervical lobe that extends along the cervical trachea.

Structure
Epithelial tissue and lymphoid tissue
Lobulated and split into cortical and medullary areas

Function
Proliferation and maturation of T cells
What can causes thymic hypoplasia?
Occurs as part of severe combined immunodeficiencies (SCID) in foals and some breeds of dogs
What can cause thymic involution?
Physiological and age-related change the is gradual and irreversible
What causes thymic atrophy?
Shrinkage of thymic organ by inadequate nutrition, intoxications, infectious agents (e.g. canine distemper virus), lack of antigenic stimuli, drugs etc.
What are the histological changes associated with thymic hypoplasia, involution and atrophy?
All have same histological changes of small numbers of lymphocytes and prominent Hassall’s corpuscles

What are the general features of primary neoplasia of the thymus?
Space occupying mass in cranial mediastinum
Dyspnoea
2 main differentials
What are the two main differentials of thymus primary neoplasia?
Thymoma
Neoplastic proliferation of epithelial cells
Slow growing, encapsulated
Dogs, sheep, goats

Thymic lymphoma
Neoplastic proliferation of T-cells
Often younger animals (cats, dogs, calves), malignant behaviour

Recall the normal structure and function of the spleen
Anatomy:
Present in the left cranial part of the abdomen within the greater omentum
Attached to the greater curvature of the stomach
Covered by a fibromuscular capsule and dissected by fibromuscular trabeculae
Varies in size and shape among species
Red pulp
Structure
Sinusoids/vascular spaces
Splenic cords
Function
Filters blood- removal of foreign material (phagocytosis)
RBC storage
Haematopoiesis (EMH)
White pulp
Structure
Periarterial lymphatic sheaths (PALS) (T-cells)
Lymphoid nodules (B-cells)
Marginal zone (Macrophages)
Function
Immune response
What is splenic amyloidosis?
Usually secondary amyloidosis, chronic inflammation (acute phase protein SAA)
What is the gross presentation of splenic amyloidosis?


Splenomegaly, beige to orange discolouration, waxy to friable appearance
What is the histological presentation of splenic amyloidosis?
Amorphous eosinophilic deposits often near blood vessels
Often macrophages and multinucleated giant cells
Congo red stain- red material turns apple-green under polarised light

What is the pathogenesis of splenic torsion?
With and without the stomach (gastric dilation and volvulus)
Twists around the gastrosplenic ligament
How does splenic torsion present grossly?
Splenomegaly, blue to black, folded back on itself (C or v shaped)

Describe siderotic plaques
Older dogs, senile changes, poss sequelae to prev. haemorrhage
Gross —> grey/white, firm encrustation on splenic capsule, usually in margins
Histo —> contains golden brown pigment (haemosiderin), blue-purple mineralisation
What are the ddxs of haemorrhage on the spleen?
Splenic haematoma, haemangioma and haemangiosarcoma all grossly indistinguishable
What are the potential sequelae to splenic haematoma
Splenic rupture
Haemabdomen
Hypovolamic shock
(indistinguishable from haemangioma & haemangiosarcoma)



What is being shown here?

Accessory spleens
What is being shown here?

Splenic congestion from barbiturate euthanasia —> spleen very enlarged and congested from storage of blood
What are the different inflammatory diseases of the spleen?
Acute splenitis:
Multifocal necrosuppurative splenitis
Septicaemia splenitis
Chronic splenitis
Granulomatous splenitis —> nodular, diffuse
What aetiological agents cause multifocal necrosuppurative splenitis?
Francisella tularensis (Tularemia)
Yersinia pseudotuberculosis (Yersiniosis)
How does multifocal necrosuppurative splenitis present grossly?
Multifocal milliary white foci within the spleen.
Can see similar lesions in the lymph nodes and liver
Older lesions resemble granulomas/ abscesses

(white dots throughout spleen = areas of necrosis)
What aetiological agents cause septicaemic splenitis?
African swine fever
Erysipelas
Anthrax
How does septicaemic splenitis present grossly?
Splenomegaly
Dark discolouration
Engorged with blood

What aetiological agent causes:
Nodular granulomatous splenitis
Diffuse granulomatous splenitis
Nodular granulomatous splenitis —> Mycobacterium avium infection (Mycobacteriosis) in a chicken

Diffuse granulomatous splenitis —> Histoplasma capsulatum (Histoplasmosis) in a dog

When is benign nodular hyperplasia seen?
In old dogs
Usually incidental
May predispose to splenic haematomas
Important to rule out neoplasia
What is the gross and histological presentation of benign nodular hyperplasia?
Gross —> grey to red nodular mass(es)
Histo —> composed of lymphoid tissue and red pulp

What is lymphoid hyperplasia and how does it present grossly?
Hyperplasia of the white pulp
Response to blood-borne antigen/chronic antigenic stimulation
Gross —> lymphoid follicles visible as 1-3 mm foci
